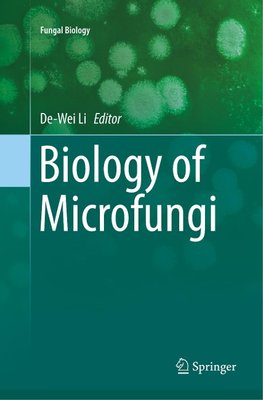
Biology of Microfungi

-
 Anglický jazyk
Anglický jazyk
Biology of Microfungi
Autor: De-Wei Li
This reference book includes 24 chapters written by a group of experts in the different fields of microfungi and cover a broad range of topics on microfungi. It provides the most updated information on the latest development in systematics and taxonomy of... Viac o knihe
Na objednávku
172.42 €
bežná cena: 181.49 €
O knihe
This reference book includes 24 chapters written by a group of experts in the different fields of microfungi and cover a broad range of topics on microfungi. It provides the most updated information on the latest development in systematics and taxonomy of microfungi, new techniques which were developed in the last ten years and their application in microfungal research. After the International Code of Nomenclature for algae, fungi, and plants (Melbourne Code) was adopted by the Eighteenth International Botanical Congress Melbourne, Australia, July 2011, it has had a profound impact on mycology and its research. Fungal nomenclature changes and its significance to fungal taxonomy and naming of microfungi in the future is discussed in detail. Since dual names system for fungi developing both sexual and asexual states, and fungi developing only asexual state is no longer available, the first five chapters will clarify some confusion and provides perspective views on the direction for future research. The next nine chapters cover microfungi and their ecological roles or functions in the different habitats (air, indoor, aquatic, marine, plants, soils, etc). The remaining 13 chapters cover the relationship of microfungi and humans (good and bad) and usage or application microfungi in different industries, such as food, agriculture, forestry, green technology, pharmaceutics, and medicine, as well as in our daily life. The book bridges the gap between basic mycological research and applied mycology and provide readers a unique set of information and knowledge of microfungi generated from multiple angles in different fields of mycology.
- Vydavateľstvo: Springer
- Rok vydania: 2018
- Formát: Paperback
- Rozmer: 235 x 155 mm
- Jazyk: Anglický jazyk
- ISBN: 9783319804989












